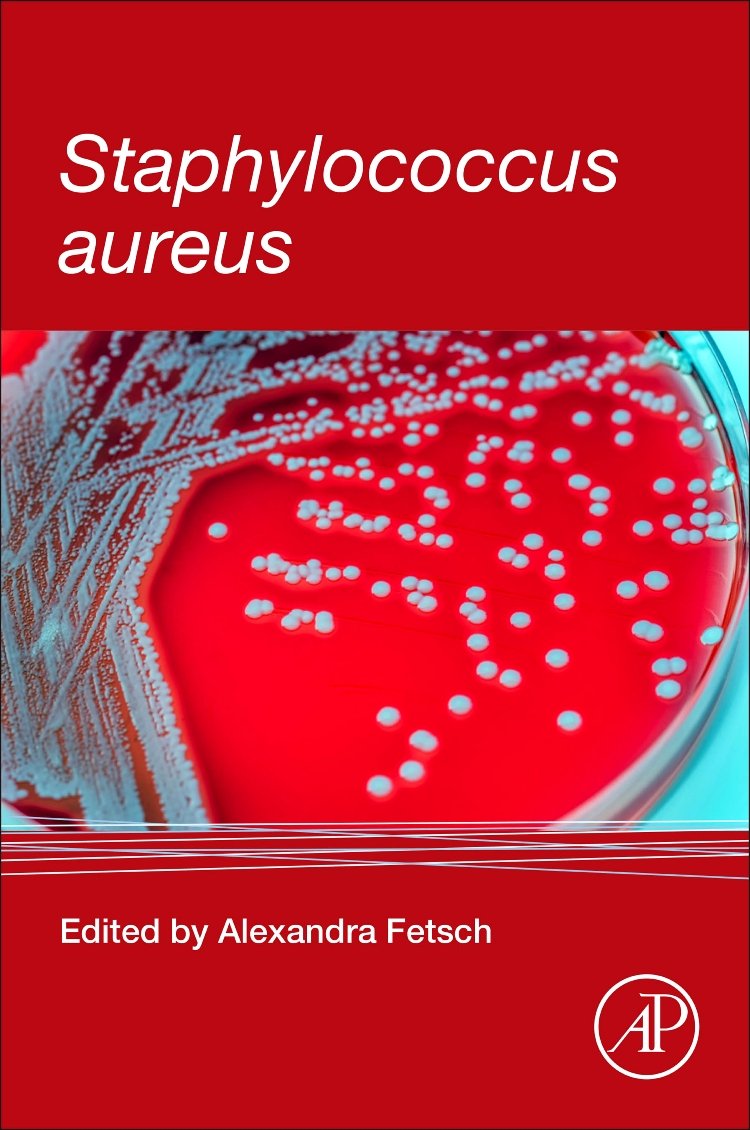
Staphylococcus aureus

Author: Fetsch, Alexandra
Brand: Academic Press
Edition: 1
ISBN: 9780128096710
Release Date: 26-09-2017
Package Dimensions: 9.4 x 7.8 x 0.8 inches
Languages: English
Binding: Paperback
Number Of Pages: 316
Details: Staphylococcus aureus provides information on food borne outbreaks of disease and their impact on human health. It is for anyone interested in the features of the pathogen, and its food safety aspects, as well as its prevalence and possible control and eradication options. This is a practical reference for those in the food industry, but also includes some theoretical information useful for advising.
The book introduces detailed features and molecular biology of the pathogen, as well as selective methods of detection, prevention and eradication essential for research. It covers methicillin-resistant staphylococcus aureus for food related industries, information on genetic lineages, cell wall components, cell division machinery, molecular characterization, and capillary electrophoresis for detecting and characterizing staphylococcus aureus. Includes information on established and novel antibiotic agents for experimental studies and methods of control and eradication Presents use cases of outbreak studies in molecular and cell biology Provides summary points of detection methods and applicability of those methods to other foodborne pathogens Covers the Staphylococcus aureus’ mode of transmission, detection, biology and impact on foodborne illness
User Reviews
Be the first to review “Staphylococcus aureus”
Vendor Information
- Store Name: Adobooks Marketplace
- Vendor: Adobooks Marketplace
- 4.71 rating from 7 reviews
Original price was: $80.88.$47.57Current price is: $47.57.

There are no reviews yet.